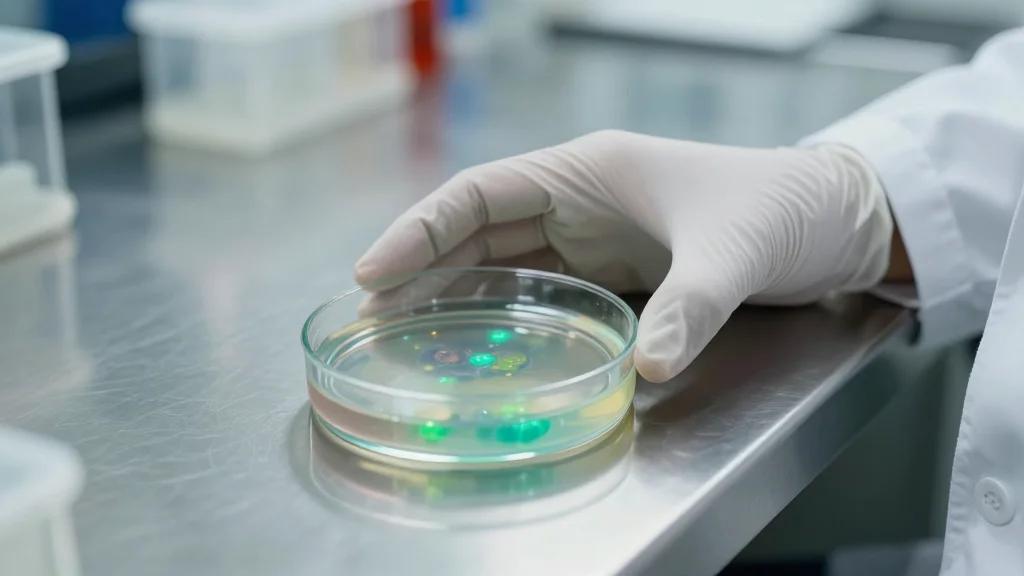
Team Trust Fuels Creative Planning and Future Success

Balance Hard Goals with Compassionate Leadership
#TimTalk - What do you mean by being tough on results but tender on people? with Urs Koenig https://t.co/TBYkZ1cTns via @DLAIgnite #SocialSelling #DigitalSelling #Sales #SalesLeader #Leadership #Culture #Marketing #Success #Mindset #Entrepreneur #Management #Inspiration https://t.co/oC53SUQHJF

Accountability Inversion: Blamers Make You the Problem
I’ve spent 20 years studying power dynamics in organizations. Here’s what no one tells you about people who avoid accountability: They don’t just dodge it. They make YOU the problem for expecting it. THE ACCOUNTABILITY INVERSION is real. Here are the 10 moves:

Value Efficiency over Busyness: Work Smarter, Rest More
We need to stop glorifying "being busy". Let's glorify: • Doing less but better • Protecting your energy • Resting before burnout • Deep work over long hours • Saying no to bad meetings • Finishing early because you were efficient

Put Top Customers and Engineers in a Chat
Protip: Create an X group chat with your best and most demanding customers. Put your engineering leads in said group chat. Respond and ship quickly. Face the music. We have one going for @v0. DM if you want to be a...

Work Smarter, Not Longer: Escape the Hustle Trap
Hustle culture is a trap. You can't outwork a bad system. I spent years working 16-hour days on a broken model. Now I spend 4 hours a day on a model that works. The goal isn't to work harder. It's...

Precision Matters: Tiny Errors Undermine Brand Reputation
Install operational xcellence One missed deliverable becomes a reputation One off-brand post becomes a signal $10M brands run on precision. Small things compound in both directions.

Hire Motivated People, Then Design a Success System
The secret to a great team is understanding that you can't actually motivate people. You must hire motivated people and build a system around them where they can succeed.

Indecisive Leaders Paralyze Teams and Halt Progress
Ever dealt with a boss who can't decide? That's the 'messy boss' – flip-flopping, no clear plan, often pleasing others or riddled with self-doubt. This indecisiveness breeds team confusion and stunts progress. #Leadership #Management #Teamwork #Business https://t.co/8vCsBYLcXh

My AI Chief of Staff Boosts Productivity, Yet Still Falters
Like a lot of folks, I’ve been slowly building my own Chief of Staff agent. It works really well for some things, like: → Evaluating my upcoming week on Sundays so Monday morning is clean → Facilitating the start and end...

Office Workers Now Spend 27% of Week in Meetings
Analysis of 50,000 office workers’ calendars, the average worker attends 13.6 meetings a week, up from 7.5 in 2019, before Covid struck. Typically, workers spend more than a quarter (27%) of their working week in some form of meeting https://t.co/ZvMTXqyUAO

Quit Bad Deals Early, Don't Waste More Time
Sellers hold onto bad deals because of sunk cost. "I've already spent 3 months on this." That's exactly why you should let it go. The time is gone either way. The question is: will you waste 3 MORE months? Ejecting from a bad deal early...

Stop Chasing Revenue, Track LTV, CAC, Payback
Most business owners focus on revenue and ignore the metrics that actually matter - lifetime value, customer acquisition cost, and payback period.

Free 4-Step Productivity Blueprint They’ll Charge $997
4-step productivity roadmap: 1. Audit your time (awareness) 2. Cut the waste (priorities) 3. Block the hours (schedule) 4. Protect the blocks (discipline) People will charge you $997 for this information. Do with it what you will.

Mastering Brevity: The Underrated Business Skill
I’m terrible at staying patient when someone's taking forever to get to the point during a workday call. Sitting there feeling the time being wasted needlessly is draining. Knowing how to relay the bottom line quickly is an underrated business skill.

Procurement Leads Sourcing, Even with Stakeholder Collaboration
“It’s often appropriate for #Procurement to involve internal stakeholders in sourcing activities. While such collaboration can be effective, ultimate responsibility for supply sourcing must lie with the Procurement function.” 🔍 https://t.co/gy1EdLnhmk #purchasing #supplychain https://t.co/7FICw45RJa

Spotlight Dashboards: One Metric, Perfectly Displayed
Most dashboards try to show everything. The best ones show one thing perfectly. I call this the Spotlight dashboard. Here's the idea. Someone asks "how's cash looking?" You don't dig through 5 tabs. You don't open 3 reports. You don't start sweating while...

Organize Your Digital Space with the PARA Method
Disorganized digital life? Use the PARA Method: structure your workspace with 4 top-level dashboards: - Projects (short-term outcomes) - Areas (ongoing responsibilities) - Resources (reference material) - Archives (inactive items)

Ruthless Prioritization: Deleted Feature Requests Mostly Stay Gone
Deleted a feature request from the backlog, only to add it back a month later? That’s not a mistake -- that’s a sign we're prioritizing ruthlessly. Almost all WON’T return, proving that overall this was wise. More: https://t.co/UJrgWx9kEr

Mutual Action Plans Give Deals Direction and Momentum
Deals without a mutual action plan are deals without a rudder. After your demo, co-create a plan with your buyer: • What steps remain • Who owns each step • When each step happens • What decision gets made at the end Buyers respect sellers who...

Open‑minded Apprenticeship Accelerates Personal and Organizational Growth
Trainees must be open-minded; the process requires them to suspend their egos while they discover what they are doing well and what they are doing poorly and decide what to do about it. The trainer must be open-minded as well,...

Productivity Fuels Expansion, Not Workforce Reduction
@pmarca is right. When a company becomes more productive, it doesn't sit still. It goes after more customers, enters new markets, builds new products. Productivity gives you leverage, and leverage makes you want to do more, not less. No CEO in history...

Solopreneurs Thrive With a Simple AI Operating System
If I wanted to guarantee a solopreneur burns out, I’d give them: 3 products 5 tools 0 operating system. I watched a friend hit $15k/month and still feel lost. Every launch was a fresh Google Doc. Every week was a “new” content plan. They didn’t need more...

Even Well‑supported Employees May Need to Be Let Go
“If an employee has been managed effectively, given support, encouragement & feedback, and adequate time & opportunity to prove themself, all to no avail, then you must take further action—even dismissal. Yet many mgrs. shy away from this.” https://t.co/gNw3MlEKqF #leadership https://t.co/eRy2hJISjb

Consistent Multi‑Channel Outreach Beats Short Email Sequences
Most cold outbound sequences are 3 emails and a prayer. The sequences that built $100M+ pipelines? 16 touches across 3 channels over 30 days. Email. Phone. LinkedIn. Burst them together on the same day for maximum visibility. Consistency beats creativity in outbound.

Choose Automation over Burnout, Not Manual Grind
You'd rather spend 40 hours a week doing tasks manually than 4 hours building systems that do them for you? Cool. You just don't get to complain about burnout.

Cultural Agility Equals Tech: Adopt AI Workflows Now
Cultural agility matters as much as tech. Teams must embrace AI-driven workflows to stay relevant in the coming decade. https://t.co/QiN3zwJ0K9

Structure Your Day in 30‑Minute Blocks for Momentum
If you feel stuck, add structure to your days. Map out your actions for an entire day in 30 minute increments. It doesn’t have to be the “right” stuff. It just needs to be something. Then stick to it for...

Desktop App Gives Coding Agents without Terminal or Cloud
This is worth seeing. Someone built a native desktop app that gives any knowledge worker full coding agent power without touching a terminal once. It's called Multica. Claude Code, OpenCode, and Codex CLI all run inside it through a clean visual interface. Your...

Create Hedge Fund Strategies with One Sentence, No Code
🚨 You can now build hedge fund-level trading strategies with zero code. Type your strategy in plain English with Horizon and it handles the logic, the backtesting, and the execution automatically. What used to cost $500K/year and a team of 5...

Competence Trumps Likeability: Leaders Must Deliver Results
True. And the boss who choses likeability over competence is idiot who will eventually ruin the company and the culture. 1st be competent. AND be likeable. Because ultimately the bill comes due and 97% of the time isn’t paid...

Cathay Pacific Slashes Flights Amid Soaring Fuel Costs
Cathay Pacific: • due to jet fuel prices, axing ~2% of CX flights between 16 May and 30 June • mostly regional flights and a small number of Australia, South Asia and South Africa flights • Dubai and Riyadh flights now cancelled...

Project Failure Rates Soar: Data Reveals Critical Gaps
Projects are failing at a higher rate than ever. We'll dive into the data and metrics that illustrate the severity of these failures, and later discuss how to address the root causes. #ProjectManagement #BusinessAnalysis https://t.co/JcOEiyZs8B
Team Trust Fuels Creative Planning and Future Success
Back safe in NYC. Had a blast visiting my team, planning the quarter ahead, and rolling up my sleeves to help with endless replating. Grateful for the faith my team has in me and their trust in my strange ideas...

Future Workplaces Will Become Flatter, Faster,
What is going to change: 1. Org structures (flat to round) 2. Compensation structures (steeper) 3. Hiring pace (slower) 4. Hiring profile (experience to taste) 5. Decision makers (the system) 6. Pace (faster) 7. Planning cycles (short) 8. Focus (less) 9. Paranoia (up) 10. AI leverage (indiv to org) Tweet below...

Disney to Cut 1,000 Jobs Across Marketing, Media
Friday afternoon scoop with @adamchitwood: Disney Layoffs of 1,000 to Begin Next Week Across Marketing, Awards and Publicity - including brands like Hulu, FX, ESPN, ABC News and Marvel. https://t.co/zT6twu2kWU

USPS Faces Bankruptcy; E‑commerce Parcels Could Be Salvation
USPS. Run out of money in 12 months. Must deliver to every address. Big drop in mail volume, especially first class. Still has discounted junk mail. Wants parcels. Logistics infrastructure for mail vs parcels. Can #ecommerce be the savior?

Implement AI in Strategy: A Step‑by‑Step Guide
Step-by-Step Guide To Integrating #AI into Your Strategic Execution by @Khulood_Almani #ArtificialIntelligence #MachineLearning #ML #Technology https://t.co/TdVIVQEGGz

AI-Driven Pre-Reads Boost Biotech Board Meeting Efficiency
I move for making biotech board meetings more efficient, effective, and even joyful. Experience directors have seconded. Here’s why/how/who. (Elephant slide, CVP, BLATT, exec session upfront, etc) And article is a Claude agent help prep pre-reads. https://t.co/lmBNvYiIzV

Connected Ecosystems, Not Isolated Systems, Unlock Freedom
I never build one system anymore. I build ecosystems. A capture system, a workflow, a feedback loop. All connected. Took me years to learn that isolated systems create chaos. Connected systems create freedom.

Treat Business Functions Like Sports: Hire Coaches
Professional athletes watch game tape. People trying to get better at golf take lessons. In all areas of life, we get coaching, training, and help to get better. Why don’t we do this for key functions of running a business?...

Leadership Culture, Not Consulting, Drives Client Success
1 Every few quarters I rework my offers to eliminate implementation consulting because it doesn't matter how solid the methodology or implementation support is... client results are ultimately beyond my control. Success or failure comes down to what extent senior...

Game Studios Show Mixed Success Adapting to AI
Our Lab just posted a new research report from Zimran Ahmed about how the game industry is adapting to AI. He spoke to people at 20 different studios and found a wide range of approaches to adapt (or failures to...

Decisions and Execution, Not Goals, Drive Results
Winners and losers have the same goals. It's not the goal setting that makes the result. The result is a sum of your decisions and consistent execution (inputs). Two examples of driving business results: 1. The quality of your decisions comes from...

Lean CEOs Show Management System Beyond Tools
📘 My favorite leadership read this week. 💡 The Lean CEO reveals the true power of Lean through in-depth interviews with CEOs who have gone beyond tool adoption and established Lean as a corporate-wide management system. Helpful resource: 🔗 https://t.co/iMuF5Swzse https://t.co/msHQOMTxFS

Craft Your Time: Free Updated Guide on Time Mastery
I wrote this piece in 2022. It went behind the paywall. The framework evolved. Now it's updated, out from behind the paywall, and better than ever. 21 minutes on why you don't manage time — you craft it => https://t.co/Bmf7m0YT9D https://t.co/V3ECpXBPgJ

Hire Right, Fire Quickly: Stop Punishing Innocents
“Fire fast.” Yes; if firing is necessary, dragging it out is worse -- for that person, the team, and yourself. But, if you’re hiring and firing fast a lot, that means you’re bad at hiring, and you 𝘩𝘢𝘷𝘦 to fix it. You’re punishing...

Verification, Not Intelligence, Limits AI; Automate Everything
Two interesting points: AI is bottlenecked as much by verification as by intelligence. Big unlock is making correctness cheap to check for messy, high stakes reasoning via auditable flows. Today automating your company is just as important as building great product.

AI Reshapes Agencies, but Core Fundamentals Stay Unchanged
AI is changing everything about running an agency. Except the parts that actually matter. I dug into the research from @sparktoro, the Design Business Council, @lennysan’s Newsletter, and a few others. I talked to a bunch of agency owners about it too. Here’s...

Funds Require Systems, Not Messy One‑Off Deals
A fund is not a deal. It’s a business. Deals can be messy and still survive. Funds can’t. If you want to raise more than once, you need systems and repeatable execution. Follow for fund builder systems. fundmanagement #raisingcapital #fundoperations #privateequity #sethbradley

Embrace Interruptions: They Spark Your Best Creative Ideas
Interruptions are not the enemy of a productive day. They're often where the best creative work happens. At the studio we call them drive-bys. And rather than treating them as disruptions, we've built them in. Meetings happen with the doors open...